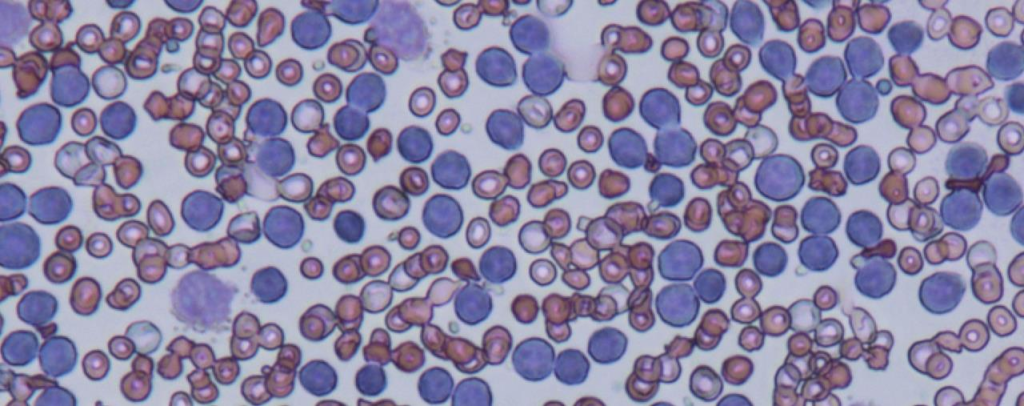

Lydia Baltazar
Abogada y Máster en Relaciones Humanas.
Hace un tiempo atrás, justo unos días después de cumplir 98 años, moría en el Quartier Latin Mr. George Whitman. Lo conocí en dos oportunidades, una saliendo del descanso de la última planta de Shakespeare & Company, allí en la salita con vistas a Notre Dame. Y la otra, también en el mismo lugar. Yo sabía de él, así que esos momentos compartidos con Mr. Whitman me resultaron bonus extras a mis visitas de la ya hermosa tienda de la Rue de Bucherie. Una de esas veces nos invitó, a mi compañero y a mí, con té frío y, con un gran entusiasmo, nos preguntó de dónde éramos: New York y Buenos Aires, se le contestó. Más le sorprendió el origen latinoamericano y me hizo varias preguntas sobre la lejana tierra mía. Aquella húmeda tarde nos contó que había recorrido toda Latinoamérica en un plan que me recordó a la travesía de Otto Mailing por paisajes patagónicos. Como no queríamos molestarlo más, aunque él parecía entusiasmado con la charla, lo saludamos, dejándolo sonriente como un duende apoyado sobre el marco de la puerta por la que apareció.

Cada vez que volvía a París y a la Rue de Bucherie, lo buscaba secretamente entre sus colchones de terciopelo rojo, entre los libros gastados e ingleses, y entre sus gatos, enrollado siempre alguno en la máquina de escribir del entrepiso; compraba algún texto clásico para que siempre nos acompañara en casa su espíritu, y al pagar era indispensable que se me estampara en la página primera el logo de Shakeaspare & Co., km 0 de Paris.
Así hoy, encontrarás por casa ‘The Tales of the two Cities’, ‘Heidi’, ‘The little prince’, ‘Pride and Prejudice’, ‘Jane Eyre’ y ‘Huckleberry Finn’ del tatatarabuelo de mi hija Julia, Mr. Mark Twain.
Mr. Whitman fue todo un personaje. Durante 60 años, no sólo se dedicó a comprar textos, sino que además ofreció asilo artístico a jóvenes escritores que, deseosos de vivir en la Cité de las Luces, encontraron allí nido a sus letras. La consigna era que cada día escribieran un capítulo, trabajaran una hora para la tienda y leyeran al menos un libro por día. En alguna ocasión, Mr. Whitman necesitó recurrir a los archivos para declarar frente a la Marie del 4to. Arrondissement que aquello no era una pensión de hippies, sino un hogar de tránsito de jóvenes escritores, llegando a albergar hasta la fecha unos 40.000.
Su excentricidad estaba basada simplemente en el buen trato, en la amabilidad y en la confianza.

“Be not inhospitable to strangers / Lest they be angels in disguise” (Seamos hospitalarios con los extraños, No sea que sean ángeles disfrazados).
Nació en New Jersey en diciembre del 13, aunque inmediatamente su familia se mudó a Massachusetts. Desde niño sus padres le transmitieron un profundo interés por toda la literatura. Cuando sólo tenía 12 años, su padre tomó toda su familia y la trasladó a China en un año que se consideró sabático. Así, inmerso en la cultura y sociedad china aprendió rápidamente la lengua. Todo este año oriental causaría una profunda impresión en él. Ya de joven editó la revista de corte satírico ‘The Reflector’. En 1935 se graduó de periodista en la Boston University y con sólo 40 dólares decidió ir a recorrer todo México y Centro América aprendiendo perfectamente el castellano en esos 5.000 kms. Este viaje, que hizo solo y a pie, lo marcaría para el resto de su vida.
Una tribu maya del Yucatán lo rescató y le salvó la vida. Pero muchos otros hombres y mujeres desconocidos le abrieron también sus casas, le dieron cobijo y comida durante esta aventura humanista. Esta actitud de generosidad y de desinteresada solidaridad, viniendo de personas en la mayoría de extrema pobreza, conmovieron a Mr. Whitman. Así, el “dar lo que puedas y tomar solo lo que necesitas”, se convirtió en su principio y lo que daría el tono al resto de su vida. Su espíritu aventurero lo llevó por muchos otros lugares, acompañando, en cierto modo, The Beat Generation de Ginsberg y Kerouac. Condujo el tranvía de San Francisco con el que escapó hasta Massachusetts, se metió un rato en Harvard e incluso más tarde, durante la Segunda Guerra, trabajó como oficial médico en diferentes hospitales europeos. Vivió entre nativos en Groenlandia y hasta contó que tuvo una hermosa novia esquimal!
Finalmente, se mudo a París en 1948 y se inscribió en la Sorbonne para estudiar filosofía, cultura, literatura y civilización francesa. Así, en esta época bohemia y acumulado ya por miles de libros en su habitación fundó ‘Le Mistra’ en el 37 Rue de la Bucherie. En aquellos tiempos, George -como quería que se llamara- visitaba la librería de su querida amiga Sylvia Beach ‘Shakespeare & Co.’, cerca del Teatro Odeón, lugar de encuentro de algunos expatriados como Hemingway, Ezra Pound, Eliot y Scott Fitzgerald. La librería de Mme. Beach fue la primera en editar el imposible ‘Ulises’ de James Joyce, después de haber sido condenado por obsceno en UK y en USA. Años más tarde en honor a su amiga, que se vio obligada a cerrar su amada librería por la ocupación nazi, y renombró a Le Mistral Shakeaspare and Company. En 1981 nació su única hija a quien nombró Sylvia Beach Whitman. Sylvia queda ahora responsable de tan fantástico legado cultural y espiritual.
Por su contribución a la cultura, en el 2006, el gobierno de Francia le otorgó la medalla de Oficial de las Artes y de las Letras.
George Whitman murió en su apartamento sobre la misma librería, acompañado de su hija Sylvia, su gato y su perro.

Shakespeare & Co., no sólo es una librería independiente sino una institución cultural morada de miles de escritores noveles del mundo entero y la gran novela viviente que Whitman acomodó entre entrepisos.
Después de 60 años dedicado a los libros, a los autores, a los visitantes, este Quijote del Barrio Latino será recordado por su espíritu libre y por su generosidad.
En estas épocas de violencia, de falta de respeto, de soberbia, petulancia y de arrolladora mala educación, sería hermoso rescatar su principio y tener el alma mas grande, la sonrisa abierta y el corazón dispuesto a ángeles extraños.